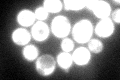
YMR235C
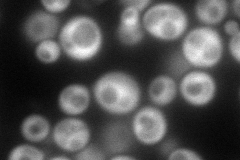
YMR235C
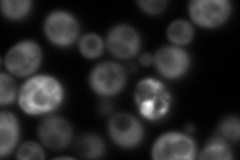
YMR235C
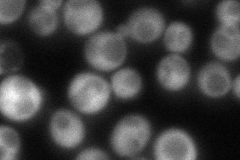
YMR235C
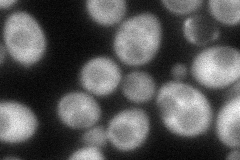
YMR235C

View description
GTPase activating protein (GAP) for Gsp1p, involved in nuclear transport
Localization:
Intensity:
Fold change:
Significance:
-
C’ GFP library in SD
cytosol131.94 -
N' NOP1pr-GFP in SD
cytosol200.649 -
N' TEF2pr-mCherry in SD
cytosol270.542 -
N' NATIVEpr-GFP in SD
cytosol100.619 -
N' TEF2pr-VC and Cyto-VN in SD
cytosol79.3745 -
C’ GFP library in SD+DTT

cytosol106.180.8No -
C’ GFP library in SD+H2O2

cytosol127.160.96No -
C’ GFP library in Starvation Media

cytosol93.680.7No -
C’ GFP library on the background of Pup2-DaMP

cytosol -
C’ GFP library on the background of CCT mutant

cytosol131.3590.995471No
